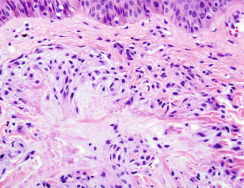

Key Terms
Xanthelasma
Xanthelasma palpebrarum
Nevus Sebaceus
Nevus syndrome
Organoid nevus
Yellow lesions of various shades—yellow, yellow-white, yellow-orange, yellow-red—include an admixture of neoplastic and inflammatory skin disorders. Usually, yellow tints are due to the accumulation of lipid or elastic fibers.
Important History Questions
How long has the lesion(s) been present?
This question is important because some of disorders in this group, such as xanthogranulomas, tend to be stable over time, whereas other conditions, such as eruptive xanthomas, are more likely to have an explosive onset. Nevus sebaceus is often present at birth, but it then becomes rather quiescent until puberty.
Has the lesion changed?
This question is important because some malignant lesions, including sebaceous gland carcinomas and a small subset of atypical fibroxanthomas (a low-grade malignancy) may also demonstrate a yellow color or yellow hue.
Do you have any known medical problems?
This query is important because some conditions, such as eruptive xanthomas, are associated with uncontrolled diabetes and primary biliary cirrhosis.
Have you or any member of your family had cancer?
Patients with numerous sebaceous gland neoplasms could suffer from Muir-Torre syndrome. This is a heritable condition that predisposes a person to gastrointestinal (GI) and renal cancers. In patients with planar xanthoma, a history of a lymphoid or myeloid malignancy, particularly multiple myeloma, would be important.
Do you take any medications?
Some medications, such as retinoids or corticosteroids, can aggravate or precipitate eruptive xanthomas.
Important Physical Findings
How old is the patient?
Nevus sebaceous can be seen in the neonatal period, but then the condition becomes largely quiescent until puberty. Xanthogranulomas are most often seen in young children. However, most other yellow skin lesions develop during adulthood.
How many lesions are present?
This is a critical finding because metabolic disorders, such as eruptive xanthomas, are characterized by numerous lesions, whereas other neoplastic disorders, such as xanthogranulomas, are typically solitary.
What is the distribution of the lesions?
Many disorders discussed in this chapter have characteristic locations. For example, tuberous xanthomas have a marked predilection for the elbows and knees, whereas xanthelasma, by definition, involves the eyelids. Sebaceous gland carcinoma also frequently involves the eyelid margin.
If multiple lesions are present, is there evidence of a Koebner phenomenon?
Only eruptive xanthomas are characterized by yellow lesions that appear with Koebner phenomena, occurring at sites of skin trauma, often in lines.
Eruptive Xanthomata
ICD10 code E78.2
METABOLIC DISORDER
Pathogenesis
Eruptive xanthomas are caused by an abrupt accumulation of low-density lipids, chiefly triglycerides, in the dermis ( Fig. 33.1 ). Eruptive xanthomas are seen in many hyperlipidemia syndromes, but the most common cause is uncontrolled or poorly controlled diabetes mellitus. Depressed insulin levels result in decreased lipoprotein lipase activity, and elevated blood glucose levels lead to elevated very-low-density lipoprotein (VLDL) levels. The net result is hypertriglyceridemia, which can lead to eruptive xanthomas in the skin. Eruptive xanthomas may also be precipitated by alcohol, oral retinoids, corticosteroids, and estrogens.
Clinical Features
- •
Eruptive xanthomas typically appear as numerous lesions, sometimes more than 100.
- •
Early lesions demonstrate variable erythema and can be pruritic or even tender.
- •
Lesions are often located on the extremities and buttocks but may appear on any cutaneous surface, including mucocutaneous junctions, such as the eyelid margins and near the vermillion border of the lips.
- •
Lesions are strikingly uniform papules, which may be folliculocentric, and are typically 2 to 5 mm in size. Color varies from red ( Fig. 33.2 ) to yellow-red ( Fig. 33.3 ) to yellow-orange ( Fig. 33.4 ) to yellow.

Fig. 33.2
Patient with uniform red papules on the buttocks, a common site for eruptive xanthomata.
(From the Fitzsimons Army Medical Center Collection, Aurora, CO.)

Fig. 33.3
Patient with eruptive xanthomas of the calf demonstrating the Koebner phenomenon.
(From the Fitzsimons Army Medical Center Collection, Aurora, CO.)

Fig. 33.4
Patient with characteristic yellow-orange papular lesions of eruptive xanthomata, with some being folliculocentric. The white color is due to application of cantharidin in the emergency room for what was thought to have been warts.
- •
The Koebner phenomenon may be present in areas of superficial trauma (see Fig. 33.3 ).
- •
Patients who present with eruptive xanthomata are also at risk for acute pancreatitis due to elevated triglyceride levels.
Diagnosis
- •
A careful clinical history, including medications and a review of systems (history of diabetes), is usually diagnostic when the clinical presentation is also supportive.
- •
At a minimum, all patients should have a complete serum lipid profile ( Fig. 33.5 ), blood glucose level, routine chemistries, and pancreatic enzymes studies performed.

Fig. 33.5
Blood from a patient with eruptive xanthomata. The blood was placed in the refrigerator to accelerate separation of the lipids.
(From the Fitzsimons Army Medical Center Collection, Aurora, CO.)
- •
A 3- or 4-mm punch biopsy can be done in problematic cases. The histologic findings can be specific or consistent with eruptive xanthoma.
Treatment
- •
Treatment focuses on the management of the underlying hyperlipidemia through diet, exercise, and lipid-lowering drugs (e.g., fibrates, statins, niacin).
- •
Remove any potentially complicating or contributing drugs, including alcohol.
- •
There is no specific treatment of the skin lesions.
Clinical Course
Eruptive xanthomas usually resolve spontaneously, over a period of 2 to 4 weeks. In most cases, there are no residual sequelae, but occasional cases may result in focal but permanent atrophy.
Xanthelasma
ICD10 code H02.6
METABOLIC DISORDER
Pathogenesis
Xanthelasma, also known as xanthelasma palpebrarum , is the most common type of xanthoma. It is estimated to occur in 1.1% of women and 0.3% of men. The pathogenesis of xanthelasma is not entirely understood. Although some patients have type II hypercholesterolemia or type III dysbetalipoproteinemia, many patients have elevated levels of cholesterol, triglycerides, and VLDL and lower levels of high-density lipoprotein (HDL) when compared to normal individuals. Similar lesions can also be seen in diffuse, normolipemic, plane xanthoma (see next section).
Clinical Features
- •
Xanthelasma is more common in women.
- •
Typically, the condition appears first in middle-aged adults.
- •
The condition may be unilateral or bilateral and may affect the upper eyelid, lower eyelid, or both.
- •
The lesions present as flat, soft, yellow-white or yellow papules or small plaques of varied size ( Figs. 33.6 and 33.7 ) on the periocular skin.







